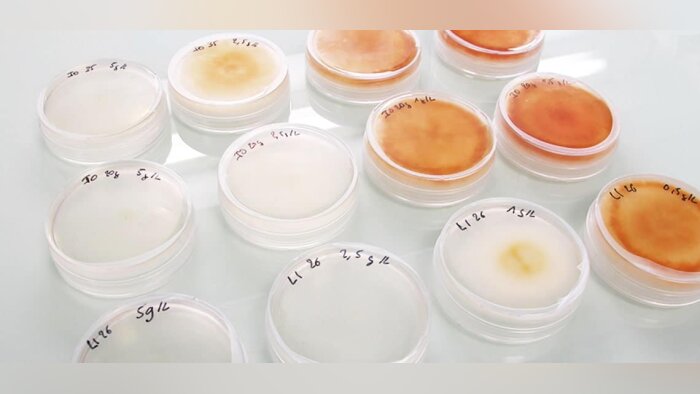

Dominique Chargé, LCA « Nous avons un besoin impératif de revaloriser l’alimentation dans notre pays »
Alors que les prix à la consommation ont augmenté de 5,8 % en juin, après + 5,2 % en mai, Dominique Chargé, président de La coopération agricole, s’est exprimé dans une tribune, afin de s’opposer aux mesures qui consisteraient à accroître les...

Agrial dévoile le détail de son plan climat 2035, certifié SBTi
Le 5 juillet, Agrial organisait une conférence de presse pour présenter son plan climat dans le détail. Cet engagement de la coopérative de réduire son impact carbone de 35 % d’ici 2035 lui a permis d’obtenir l’ambitieuse certification SBTi. Une...

Nouvelle responsable développement Sud-Est chez Vivagro
Chez Vivagro, la responsable développement régional Sud-Est est arrivée : Maëlle Ruat remplace Mélanie Corre, qui a dernièrement pris le poste de responsable technique. Maëlle Ruat sera en charge de développer l’approche Physioprotech de la...
Les Culturales 2023 se dérouleront les 14 et 15 juin
La 16e édition des Culturales aura lieu les 14 et 15 juin 2023, à Congerville-Thionville, commune de l’Essonne située à la limite avec l’Eure-et-Loir. Ce salon de plein champ, dédié aux producteurs de grandes cultures et organisé tous les deux...
Bientôt une microalgue antifongique en traitement de semences
La startup ImmunRise Biocontrol annonce avoir levé 5 M€ pour finaliser le développement d’une microalgue antifongique. L’entreprise ambitionne de mettre sa solution sur le marché dès 2026, en traitement de semences grandes cultures et potagères...
Maïsadour obtient le label RSE « confirmé »
Maïsadour a annoncé, le 4 juillet, avoir obtenu le Label Engagé RSE « confirmé ». La démarche de labélisation, entamée en novembre 2020, s’est déroulée avec l’Afnor et La coopération agricole. Un référentiel RSE interne a été conçu, et des...
Soutien de FranceAgriMer, six mois supplémentaires accordés
Parue au Bulletin officiel du 30 juin 2022, la décision n° INTV-SIIF-2022-44 du 29 juin modifie plusieurs précédentes décisions relatives aux programmes d’aides aux investissements donnant lieu au soutien financier de FranceAgriMer : pour...

Stella Kyriakides, commissaire européenne - « Nous lancerons une évaluation sur les indicateurs de risques harmonisés »
Une semaine après la présentation du projet de révision de la directive Sud, par la Commission européenne, la commissaire européenne chargée de la santé et de la sécurité alimentaire, Stella Kyriakides, a indiqué, le 30 juin, devant la commission...

InVivo et TotalEnergies inaugurent un démonstrateur agrivoltaïque en Ile-de-France
InVivo et TotalEnergie ont inauguré le 29 juin le premier démonstrateur agrivoltaïque francilien à Valpuiseaux en Essonne, d’une surface de 5000 m2 et d’une puissance de 111 kWc, dans le cadre de leur partenariat « pour favoriser les transitions...

Les membres de la CNCE très réservés sur l’évolution de la HVE
Après plusieurs semaines de travail, la Commission nationale de la certification environnementale, CNCE, a enfin voté les modifications proposées par le gouvernement sur la refonte du référentiel HVE. Le texte a été adopté de justesse, les...

Le service marketing de Bayer s’étoffe
Constance Tuffet rejoint l’équipe marketing cultures de Bayer Crop Science France. Elle est en charge, depuis le 1er juillet 2022, des céréales, oléoprotéagineux, pommes de terre et betteraves, sous la direction de Sophie Huvier-Boutin.Son poste...

Nomination à la la direction du pôle animal de La coopération agricole
La coopération agricole a nommé Gaëlle Dupas à la direction du pôle animal, le 1er juillet 2022. Âgée de 45 ans, elle est ingénieure agronome, et dispose de plusieurs expériences autour de l’élevage, au national comme en région. Elle a ét...

Agroécologie, BASF fait le point sur ses avancées concrètes
Deux ans après l’annonce de sa feuille de route agroécologique à horizon 2030, BASF Agro a fait un point d’étape sur ses avancées en la matière. Co-construction et innovation sont mises en avant pour progresser et déployer les solutions...

2021, année record pour les biostimulants
Après deux années de recul, 2021 a vu le marché des biostimulants s’envoler, en valeur comme en surface. La conjoncture a été favorable à cette poussée, et la pratique semble s’installer dans les itinéraires culturaux. 2021 a été une année record...

FMC en passe d’acquérir BioPhero
FMC devrait acquérir, avant la fin de 2022, la société danoise BioPhero spécialisée dans le développement et la production de phéromones à bas coût. Un accord vient d’être signé en ce sens. FMC annonce le 29 juin 2022 avoir passé un accord pour...

Jean-Marc Petat, BASF - « Sans soutien des innovations, la baisse de 50 % des phytos aura un impact négatif »
Interrogé sur le projet de règlement de la Commission européenne relatif à l’utilisation durable des pesticides, lors d’une conférence de presse organisée par sa société le 30 juin 2022 sur l’agroécologie, Jean-Marc Petat, directeur agriculture...